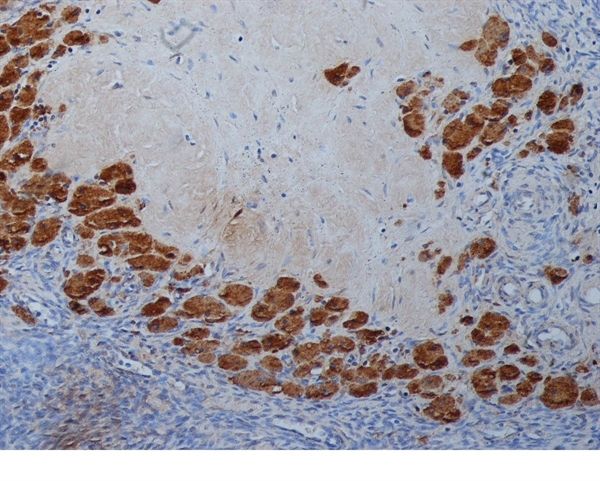
Progesterone antibody [9B4]

相关产品推荐更多 >
万千商家帮你免费找货
0 人在求购买到急需产品
- 详细信息
- 文献和实验
- 技术资料
- 免疫原:
Progesterone conjugated to bovine serum albumin at position 3.
- 亚型:
IgG1
- 形态:
Liquid
- 保存条件:
Store as concentrated solution. Centrifuge briefly prior to opening vial. For short-term storage (1-2 weeks), store at 4ºC. For long-term storage, aliquot and store at -20ºC or below. Avoid multiple freeze-thaw cycles.
- 克隆性:
Monoclonal
- 标记物:
Unconjugated
- 适应物种:
Human
- 保质期:
12 months from the shipping date of the product.
- 目录编号:
GTX39285
- 级别:
Primary Antibodies
- 库存:
Available
- 供应商:
GeneTex
- 宿主:
Mouse
- 应用范围:
IHC-P, ELISA
- 浓度:
0.5 mg/ml (Please refer to the vial label for the specific concentration.)
- 靶点:
Progesterone
- 抗体英文名:
Progesterone antibody [9B4]
- 抗体名:
Progesterone 抗体 [9B4]
- 规格:
1 mg
IHC-P analysis of human ovary tissue using GTX39285 Progesterone antibody [9B4].
IHC-P analysis of human ovary tissue using GTX39285 Progesterone antibody [9B4].
风险提示:丁香通仅作为第三方平台,为商家信息发布提供平台空间。用户咨询产品时请注意保护个人信息及财产安全,合理判断,谨慎选购商品,商家和用户对交易行为负责。对于医疗器械类产品,请先查证核实企业经营资质和医疗器械产品注册证情况。
文献和实验Duan L et al., Endocrine 2019 (PMID:31456041)
技术资料暂无技术资料 索取技术资料

![FABP4 antibody [9B8D]](https://img1.dxycdn.com/2022/0328/684/8138916435577500453-14.jpg!wh200)
![CDK2 (phospho Tyr15) antibody [HL1474]](https://img1.dxycdn.com/2022/0615/559/1975114919791064553-14.jpg!wh200)
![RAIDD antibody [AT14G8]](https://img1.dxycdn.com/2022/0328/166/2591209162960800453-14.jpg!wh200)



